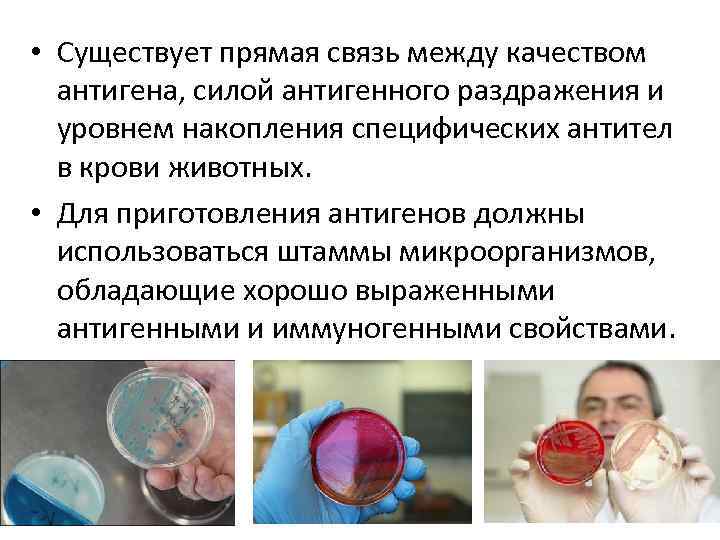
• Существует прямая связь между качеством антигена, силой антигенного раздражения и уровнем накопления

сыворотки и иммуноглобулины.ppt
- Количество слайдов: 51

Производство лечебно профилактических и диагностических сывороток и иммуноглобулинов к. б. н. Емельянова Е. К.

Вопросы • Гомологичные и гетерологичные иммунные препараты. • Отбор животных продуцентов. • Грундиммунизация животных продуцентов. • Гипериммунизация животных. • Технологическая схема приготовления гипериммунных сывороток. • Этапы получения гипериммунных сывороток. • Контроль качества сывороточных препаратов. • Биотехнология производства гамма глобулинов.

• Иммунные сыворотки получают из крови искусственно иммунизированных животных и людей доноров (в этих целях используют периферическую, плацентарную и абортную кровь). • Для получения высоких титров AT лошадей и кроликов иммунизируют дробным введением соответствующих Аг в больших дозах. Препараты, изготовляемые из крови животных, содержат гетерологичные AT, поэтому человеку такие гетерологичные (чужеродные) сыворотки вводят при соблюдении мер предосторожности. • Препараты, изготовляемые из крови иммунизированных доноров, содержат гомологичные AT; гомологичные сыворотки лишены многих побочных эффектов гетерологичных сывороток. Гомологичные сыворотки применяют для профилактики и лечения вирусных гепатитов, кори, столбняка, ботулизма и др. • После введения гетерологичных сывороток состояние невосприимчивости длится 2 3 нед, эффект гомологичных AT сохраняется 4 6 нед.

• Лечебно профилактические и диагностические иммунные сыворотки используют для профилактики инфекционных заболеваний, лечения больных, а также для серологических методов диагностики болезней. • Гипериммунные сыворотки представляют собой сыворотки крови животных, систематически иммунизированных бактериальными или вирусными антигенами, содержащие антитела, обладающие строго специфическим действием на бактериальные токсины, патогенные бактерии или вирусы, против которых иммунизировали животных.

• Изготовление лечебно профилактических гипериммунных сывороток представляет сложный, длительный и многогранный технологический процесс, в котором участвуют врачи микробиологи, биотехнологи, биохимики, зооинженеры, рабочие аппаратчики, работники электротехнической службы. • Технология производства гипериммунных сывороток объединяет ряд подразделений биопредприятий, главным из которых является сывороточный цех.

Классификация гипериммунных сывороток • По природе антигена Антитоксические Антибактериальные Противовирусные • По направлению действия Лечебные Профилактические Диагностические • По специфическому действию на антигены Нейтрализующие Преципитирующие Агглютинирующие Лизирующие (комплементсвязывающие)

Структура сывороточного цеха включает: • • Карантинное отделение Иммунизационные клиники Антигенные лаборатории Отделения получения, концентрирования и очистки сывороток. При создании гипериммунных сывороток требуются стерильные условия. Боксы должны обеспечиваться притоком стерильного воздуха. Рабочие места, стены, потолок, пол подвергаются влажной уборке с дезрастворами и УФ облучению. Остальные помещения должны иметь приточно вытяжную вентиляцию. Сжатый воздух, вакуум, холодная, горячая, дистиллированная, деминерализованная вода подаются по системе трубопроводов. • В сывороточном цехе должны иметься автоклавные, термостатные, рефрижераторные помещения, холодильники.

Основными задачами иммунизационных отделений являются: • Отбор животных • Иммунологическая подготовка животных продуцентов • Содержание и кормление животных • Иммунизация животных • Кровопускание • Ветеринарно санитарное и зоотехническое обслуживание животных.

• Для приготовления гипериммунных сывороток чаще всего используют лошадей и крупный рогатый скот (волы). При производстве сыворотки против рожи используют свиней. • Животных, применяемых для получения сывороток, завозят из стационарно благополучных по инфекционным болезням районов. Они должны быть клинически здоровыми, средней и выше средней упитанности, свободными от накожных паразитов.

На получение высокоэффективных лечебно профилактических сывороток влияют: • качество применяемых антигенов (в частности, их чистота, объем и концентрация); • неспецифические раздражители и адъюванты; • индивидуальные особенности животных продуцентов (в частности, их способность к иммунобиологической перестройке при создании у них грундиммунитета, для чего необходим тщательный отбор животных продуцентов); • метод и схемы гипериммунизации; • содержание и кормление животных в период их подготовки и эксплуатации.
• Существует прямая связь между качеством антигена, силой антигенного раздражения и уровнем накопления специфических антител в крови животных. • Для приготовления антигенов должны использоваться штаммы микроорганизмов, обладающие хорошо выраженными антигенными и иммуногенными свойствами.

Качество антигенов зависит от следующих факторов: • Чистота (неконтаминированность посторонней микрофлорой); • Степень очистки антигенов от балластных белков; • Концентрация.

• При изготовлении гипериммунных сывороток применяют антигены, специфическое действие которых усилено адъювантными веществами, в качестве которых используют гель гидроокиси алюминия, алюминиевые квасцы и др. • В практике производства антитоксических сывороток широко используют хлористый кальций, алюмокалиевые квасцы, адьюванты типа Фрейда, тапиока.

Отбор животных-продуцентов. Грундиммунизация Получение гипериммунных сывороток осуществляется в несколько этапов: • Подбор животных продуцентов. • Грундиммунизация (грундирование) отбор животных из числа завезенных, путем создания у них основы иммунитета. • Гипериммунизация животных продуцентов. • Приготовление сывороточных препаратов.

Подбор животных-продуцентов • Всех завезенных на биофабрику животных выдерживают в карантине 45 суток. За это время их всесторонне обследуют с ежедневным (утром и вечером) двукратным измерением температуры тела, проверяют на пораженность гельминтами и при необходимости дегельминтизируют. • Всех животных исследуют на инфекционные болезни согласно требованиям нормативно технической документации. • Лошадей исследуют на сап, трихомоноз, бруцеллез, туберкулез, пироплазмидозы, инфекционную анемию; крупный рогатый скот на туберкулез, бруцеллез, лептоспироз, лейкоз; свиней на туберкулез, бруцеллез; овец на бруцеллез, туберкулез, паратуберкулез и др. • При отборе животных продуцентов учитывают их физиологические и иммунобиологические показатели.

На активность выработки животным продуцентом гипериммунной сыворотки антител влияют: • Тип нервной деятельности животного продуцента. • Реактивность организма. • Порода. • Пол. • Конституция. • Возраст.

Лошадей используют в возрасте от 3 до 12 лет, помеси донской и казахской пород, массой 450 — 500 кг; волов в возрасте от 3 до 8 лет, массой не менее 350 кг, красностепной, калмыцкой, симментальской, швицкой астраханской пород; свиней в возрасте 5 6 месяцев, массой не менее 80 кг, крупной белой породы; овец, баранов в возрасте 2 3 лет и массой 30 45 кг (для получения диагностических сывороток и сывороточных сред).

• Учитывая, что введение антигенов животным и периодическое кровопускание приводят к нарушению обмена веществ и анемии (а в ряде случаев и к снижению титров антител), главное внимание уделяют вопросам полноценного, сбалансированного кормления животных-продуцентов, которое отличается от кормления других животных и осуществляется по специально разработанным и утвержденным рационам.

• Для восстановления крови после крововзятия важно правильно организовать минеральное кормление животных. На 1 кг сухого корма лошадей должно приходиться: железа 145 165 мг; меди 15 18 мг; кобальта 1, 2 1, 4 мг; марганца 9 мг. • Для восстановления красной крови лошадям вводят в рацион эритроциты, фибрин, кормовые антибиотики, проращенный овес. Иногда проводят реинфузию эритроцитов.

Грундиммунизация животныхпродуцентов • Теоретически обосновано и практически целесообразно отбирать животных продуцентов по иммунологическим показателям. • Груидиммунизация (грундирование) это метод отбора животных продуцентов, обладающих высокой реактивностью организма и способных выработать антитела против введенного антигена в высоких титрах.

• При отборе животных продуцентов их проверяют на наличие антител к тому или иному антигену серологическими методами. Например, отбор лошадей продуцентов для производства противодифтерийной сыворотки проводится по титру естественного противодифтерийного анатоксина в крови животных, выявляемого в реакции нейтрализации. • Если антител в крови животных не обнаруживают, их грундируют, т. е. вводят антиген и по нарастанию титра антител, в результате грундиммунизации, отбирают лошадей продуцентов про тивостолбнячной, противоботулинической, противодифтерийной и других сывороток.

• При проведении грундиммунизации животным дважды вводят убитый антиген или живые атенуированные микроорганизмы (убитые или живые вакцины) внутримышечно или подкожно с интервалом в 2 3 недели. • До начала грундиммунизации и через 7 — 8 суток последнего введения антигена у животных берут кровь и определяют в ее сыворотке наличие антител к тому антигену, с помощью которого в последующем готовят гипериммунную сыворотку.

• Выявление в сыворотке крови антител в титрах 1: 800 и выше указывает на то, что данное животное может быть использовано как продуцент гипериммунной сыворотки, т. е. такое животное обладает высокой реактивностью организма и иммунная система его способна вырабатывать антитела в необходимых титрах. • Кроме того, организм животного сенсибилизируется, «знакомится» с антигеном и при последующей гипериммунизации быстро ответит на введение антигена выработкой антител.

• Предварительное, правильно проведенное грундирование животных обеспечивает повышение (в 5 раз и более) титров специфических антител при последующей гиперимунизации тем же антигеном, увеличивает выход высокоактивного препарата и создает условия получения сывороток в более короткие сроки. • Всех животных, у которых при грундиммунизации не обнаружи вают антител или обнаруживают в титре менее 1: 800, подвергают выбраковке.

Гипериммунизация животных Гипериммунизация это метод парентерального введения животным нарастающих доз соответствующих антигенов с целью получения наивысшей ответной иммунологической реакции организма, а следовательно, и максимального увеличения в крови животных титра специфических антител, который должен обеспечить лечебный, профилактический и диагностический эффект препаратов.

• При гипериммунизации состав сыворотки крови меняется. Обычно нарастает количество общего белка, увеличивается количество гамма и бета глобулиновых фракций, уменьшается содержание альбуминов. • Так, если в нормальной сыворотке крови лошадей альбумины со ставляют 50 % от общего количеств белков, то в иммунной сыворот ке их бывает 35 % и ниже.

• Успех гипериммунизации животных продуцентов во многом зависит не только от тщательного их подбора, качества антигена и адьювантных веществ, но и от правильно выбранной схемы гипериммунизации, правильной технологии выполнения этих схем, а также технологии кровопускания или обескровливания продуцентов в конце их эксплуатации.

Введение антигена • Антиген вводится обычно подкожно или внутримышечно в несколько мест с таким расчетом, чтобы точки инъекции находились вблизи лимфатических узлов. При этом в иммуногенез быстрее вов лекается большое количество лимфоузлов, что повышает общую и иммунологическую реактивность организма. Введение антигена одновременно в несколько мест обеспечивает лучшую рассасываемость его и появление более равномерных и менее болезненных инфильт ратов. • Антигены в небольших дозах (5 25 мл) обычно вводят подкожно в верхнюю часть шеи животного, а в больших количествах в область спины и крупа внутримышечно.

Пример получения гипериммунной противосибиреязвенной сыворотки • Для гипериммунизации чаще всего используют лошадей. Цикл гипериммунизации обычно длительный и составляет 1 2 и более месяцев. • Например, для получения гипериммунной противосибиреязвенной сыворотки используют лошадей в возрасте от 3 до 10 лет. • Вначале здоровым животным вводят четырехкратно вакцину Ценковского II для создания стойкого иммунитета (грундиммунизация), а потом лошадей подвергают гипериммунизации вирулентной суточной бульонной культурой возбудителя сибирской язвы. • Всего используют 12 вирулентных штаммов возбудителя, комбинируя их по четыре в виде смеси для каждой иммунизации.

Пример получения гипериммунной противосибиреязвенной сыворотки (продолжение) • Гипериммунизацию лошадей начинают с малых доз: 0, 5; 1, 0; 2, 5 и 5, 5 мл с интервалом в трое суток. Затем культуры возбудителя сибирской язвы вводят с интервалами в 3 4 суток и в дозах 10, 0; 20, 0; 40, 0; 80, 0; 100, 0; 110, 0 120, 0; 130, 0; 140, 0; 150, 0 мл. • Обычно бывает достаточным ввести антиген 13 раз и сыворотка лошадей продуцентов становится активной. При введении доз от 10 до 80 мл к культуре добавляют 0, 2 % алюминиевых квасцов, а к дозам от 100 до 150 мл 0, 1 % квасцов. При повышении у животных температуры тела интервал между инъекциями увеличивают до 4 или 5 суток. • В каждом конкретном случае схемы иммунизации могут быть разными и отличаются одна от другой даже при получении одной и той же сыворотки.

Разнообразие схем иммунизации определяется • • • различием методов введения антигена; дозировкой антигена; количеством инъекций; интервалами между инъекциями; объемом забираемой у животного крови; кратностью цикловых кровопусканий.

Отбор крови • По окончании гипериммунизации, когда в сыворотке крови животного установлен максимальный титр специфических антител, у него берут кровь обычно через 7 10 суток последней инъекции антигена. Этот период соответствует максимальному накоплению антител в крови животных и полностью укладывается в закономерности иммуногенеза.

Количество забираемой крови зависит: • от массы животного; • от привычки его к кровопотерям с учетом начального и последующих циклов; • количества предполагаемых кровопусканий в данном цикле; • количества титра антител; • состояния здоровья животного.

• К взятию крови животных приучают постепенно. • Обычно при каждом крововзятии кровь берут из яремной вены из расчета 800 мл на каждые 50 кг массы животного (или 13 % к общей массе крови животного).

Приготовление гипериммунных сывороток • Сыворотку получают методом цитрирования крови с последующим сепарированием и дефибринированием плазмы. • Сыворотку крови консервируют 0, 5 % ным раствором фенола и отстаивают в емкостях в течение двух месяцев.

• При получении большинства противовирусных гипериммунных сывороток используют антигены без адъювантов, отстаивают в специальных емкостях в течение двух месяцев. Отстоявшуюся сыворотку фильтруют вначале через пластины Ф, а затем через стерилизующие пластины СФ. В последующем сыворотку расфасовывают во флаконах емкос тью по 100 мл. • Флаконы закрывают пробками и для герметичности их обкатывают алюминиевыми колпачками. На флаконы наносят эти кетку и часть продукции сдают на контроль.

Технологическая схема приготовления гипериммунных сывороток

Этапы получения гипериммунных сывороток

Линия производства сывороток 1 сепаратор; 2 дефибринатор; 3 отстойник; 4 фильтр предварительной очистки; 5 фильтр стерилизующей филь трации; 6 сборник готовой продукции

• Принципы очистки сывороток основаны на выделении из них активных белковых фракций (преимущественно гамма глобулинов) и удалении балластных фракций, не являющихся носителями антител (например, альбумины). • Выделенные фракции растворяют в меньшем объеме растворите ля, по сравнению с исходным объемом, что позволяет препарат сконцентрировать и вводить в меньших дозах.

Необходимость в получении концентрированных сывороток связана: • со значительными объемами выпускаемых лечебных сывороток исчисляемыми сотнями тонн. Для расфасовки сывороток требуется большое количество флаконов, пробок, колпачков, ящиков для упаковки. Кроме того, большие затраты уходят на транспортировку такого объема сывороточных препаратов • с недостаточно высокой активностью отдельных сывороток, которые вводятся животным в больших дозах (с профилактической целью по 20 60 мл, с лечебной по 40 120 мл). Уменьшения общего объема выпускаемых сывороток и повышения их активности можно достигнуть путем их очистки и концентрации иммуноглобулинновой фракции гипериммунной сыворотки.

В производственных условиях очистку и концентрацию сывороток проводят чаще всего комбинированным способом, включающим: ферментативный гидролиз; прогрев ферментированных сывороток в кислой среде; солевое фракционирование; дополнительную очистку от неактивных белков с использованием органических растворителей, сорбентов; • дополнительное выдерживание сывороток при пониженных температурах. При такой обработке удаляется до 80 85 % балластных белков сыворотки. • •

Контроль качества сывороточных препаратов • Контроль за качеством сывороток осуществляют на всех стадиях их изготовления. • После производственного контроля каждая серия сыворотки проверяется по физическим показателям (цвет и консистенция), на стерильность, безвредность, правильность объема расфасовки в разные емкости (ампулы или флаконы), герметичность их укупорки, качество этикетировки, маркировки и упаковки, а также специфическую активность после 20 дневного выдерживания при (37 ± 1) °С. • Проводят также контроль сывороточных препаратов на содержание белка, водородных ионов (р. Н), электрофоретическую чистоту и др. (апирогенность, остаточное содержание солей). • Сывороточные препараты должны быть стерильными (не контаминированы бактериями и вирусами), безвредными и высокоактивными специфическими препаратами.

Контроль качества сывороточных препаратов (продолжение) • Контроль бактериальной стерильности проводят по общепринятой методике высевами из препарата на питательные среды МПА, МПБ с глюкозой, на агар Сабуро или среду Чапека для исключения грибковой микрофлоры. • Безвредность каждой серии сывороточных препаратов проверяют на морских свинках, кроликах. Животные должны оставаться здоровыми и не иметь заметной местной и общей реакции в течение 10 дневного наблюдения. • Специфическую активность сывороточных препаратов определяют биологическим и серологическим методами. Для определения биологической активности используют восприимчивых лабораторных животных, эмбрионы птиц или культуры клеток.

• Активность сывороточных препаратов определяют по сравнению со стандартными (эталонными) референс препаратами. • Для этого сыворотку с неизвестной активностью используют параллельно со стандартной сывороткой, а затем рассчитывают дозу испытуемой сыворотки, эквивалентную по эффекту единице активности стандарта.

Биотехнология производства гамма глобулинов • В предупреждении инфекционных болезней и лечении больных животных большую роль играют глобулиновые препараты. • К ним относят «неспецифический» (нормальный) гамма-глобулин, полученный из сыворотки крови здоровых животных, а также иммунные глобулины, выделенные из гипериммунных сывороток переболевших животных (сыворотка животныхреконвалесцентов).

• Глобулины сыворотки крови делятся на три фракции: α-, β-, γ-глобулины. • Гамма глобулин представляет собой белковую фракцию крови, которая выполняет функцию защитных антител в организме и обладает наименьшей электрофоретической подвижностью.

Методы получения гамма глобулинов • применяют спиртовой, солевой, риваноловый, эфирно спиртовой методы, а также осаждение их солями тяжёлых металлов и выделение при помощи ионообменных смол и др. • Г. г. получают из донорской или плацентарной крови, а специфичные Г. г. выделяют из сывороток животных, иммунизированных соответствующими антигенами.

Этапы производства гамма глобулина (Воронин, 2008)

Технология приготовления гамма глобулина риваноловым методом

• Биотехнология. Под редакцией академика Е. С. Воронина, изд. ЗАО ГИОРД, 2008 г.
сыворотки и иммуноглобулины.ppt